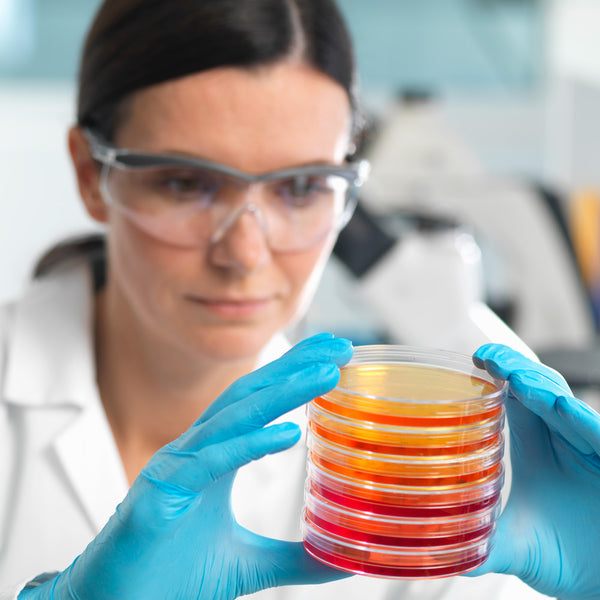

References
1. Sekikawa T, Kizawa Y, Li Y, Takara T. J Clin Biochem Nutr. 2020;67(3):307-316. doi:10.3164/jcbn.19-116
2. Shah MMR, Liang Y, Cheng JJ, Daroch M. Front Plant Sci. 2016;7. doi:10.3389/fpls.2016.00531
3. Medoro A, Intrieri M, Passarella D, Willcox DC, Davinelli S, Scapagnini G. J Funct Foods. 2024;112:105937. doi:10.1016/j.jff.2023.105937
4. Galasso C, Orefice I, Pellone P, et al. Mar Drugs. 2018;16(8):247. doi:10.3390/md16080247
5. Pereira CPM, Souza ACR, Vasconcelos AR, Prado PS, Name JJ. Int J Mol Med. 2021;47(1):37-48. doi:10.3892/ijmm.2020.4783
6. Donoso A, González-Durán J, Muñoz AA, González PA, Agurto-Muñoz C. Pharmacol Res. 2021;166:105479. doi:10.1016/j.phrs.2021.105479
7. Queen CJJ, Sparks SA, Marchant DC, McNaughton LR. Nutrients. 2024;16(6):826. doi:10.3390/nu16060826
8. Si P, Zhu C. Mol Med Rep. 2022;26(4):300. doi:10.3892/mmr.2022.12816
9. Park JS, Chyun JH, Kim YK, Line LL, Chew BP. Nutr Metab. 2010;7(1):18. doi:10.1186/1743-7075-7-18
10. Ng QX, De Deyn MLZQ, Loke W, Foo NX, Chan HW, Yeo WS. J Diet Suppl. 2021;18(2):169-182. doi:10.1080/19390211.2020.1739187

)